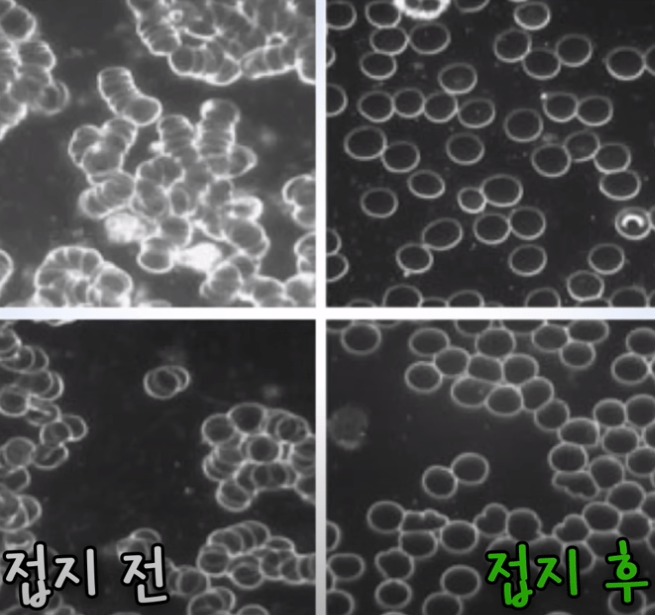

사진 터치. 위·아래로 이동 스크롤(Scrolling)해서 읽기, 위쪽 노란색 카톡 아이콘 터치해서 전달 가능, 블로그 제목 터치하면 해당 블로그 읽기 가능. 최신 블로그는 공유 할게요.
———————
동의보감에 이런 말이 있다.
『약을 써서 몸을 보호하는 약보(藥補)보다는
좋은 음식으로 원기를 보충하는 식보(食補)가 낫고,
식보보다는 걷는 행보(行補)가 낫다』
걷기는 건강에 최고다.
맨발 걷기를 한다면, 자연의 상태로 걷는 것이니 금상첨화 다.
맨발 걷기, 어싱을 강력 추천 하면서, 왜 좋은지를 공유 합니다.
맨발 걷기는 Bare foot walking 이고, 어싱은 접지 Earthing 이다.
아파트 앞 공원의 맨발 걷기 (아래 사진)

맨발 걷기 , 수원 영통 독침산 (아래)

광교산 맨발 걷기, 친구들 인증 샷 (2023.8.26, 아래)

수원 영통에도 맨발 걷기에 좋은 독침산 (해발 109 m) 도란길이 있다.
독침산 (일명 독지미산)은 뱀이 많아서 산 이름이 독침산으로 정해졌다고 한다.
독침산 맨발 걷기로 정상과 도란길 둘레길 코스로 걸으면 약 1시간 정도면 충분하다.
발의 구조와 기능
인간의 신체는 206개 뼈로 구성되어 있다.
그 중 두 발에만 52개 뼈가 있다. 우리 몸의 뼈의 25퍼센트가 발에 있다.
한쪽 발은 뼈 26개, 관절 33개, 근육 64개, 인대 56개, 7,000개의 신경, 수많은 혈관으로 이뤄져 있다.
발은 『제 2의 심장』 으로 불린다.
왜냐하면, 발은 심장에서 보낸 혈액을 받아서, 다시 온몸으로 보내는 펌프 작용을 하기 때문이다.
발에 문제가 생기면 남의 도움 없이는 생활할 수 없다
70 킬로그램 성인이 하루 만 보를 걷는다면, 발은 하루 700톤의 무게를 지탱해야 한다.
그래서, 발은 무게를 지탱하기 위해 아치 형태를 이룬다.
발에 있는 족저근막은 아치 형태를 유지하는데 중요한 역할을 한다.
인간은 원래 땅을 맨발로 걸어 다니는 존재였다.
고대 시대부터 인간은 맨발로 태어나서 맨발로 다니도록 진화, 발달해 왔다.
하지만, 현대인은 아장 아장 걷기 시작 하면서 부터 신발을 신고 다닌다. 발이 과잉 보호를 받게 되면서 발은 퇴화했다.
과잉 보호를 하게 되면, 모든 것이 약해지고 퇴화한다.
신발을 신으면서 잃어 버린 것
발의 여러 잔 근육들을 풋 코어 근육이라고 한다.
첫째, 발가락을 오리고 벌리는 풋 코어 근육이 퇴화 했다.
둘째, 신발을 신으면서 척수 반사, 균형 감각이 떨어지게 되었다.
발가락 건강 확인 테스트
첫째, 발가락 5개가 모두 짝 벌어지는가?
둘째, 5개 발가락을 모두 바닥에 붙인 다음, 엄지 발가락만 들어 올릴 수 있는가?
발의 풋코어 근육에 문제가 생기면
첫째, 족저근막염, 무지외반증, 지간신경종 등 여러가지 발 질환의 원인이 된다.
신발로 발을 보호하면서 발의 감각은 퇴화한다. 발에는 7,200개 신경, 20,000개 신경 말단이 있다. 어린 아기는 발을 만지면 간지럽다고 하는데, 어른이 되면 간지럽다고 느끼는 사람은 거의 없다. 발의 감각이 퇴화했기 때문이다.
둘째, 반사 신경과 균형 감각이 떨어진다.
척수 반사란 척수에서 처리하는 능력인데, 척수 반사 능력이 떨어진다.
방에서 넘어져 뼈가 골절 되는 노인은 반사 신경과 균형 감각이 떨어졌기 때문이다.
맨발 걷기 이론 (박동창 회장)
첫째, 지압 이론
땅의 굴곡이 발바닥을 자극하여 얻게 되는 지압 효과 다.
발바닥에는 오장 육부와 뇌까지 연결된 지압점들이 가득하다. 숲길에서는 돌멩이, 나무 뿌리, 나뭇가지 등이 발바닥의 무수한 지압점을 자극한다. 전신의 혈액 순환이 좋아지게 된다.
둘째, 접지 이론
접지란 내 몸이 땅에 직접 접하는 것이다.
맨발 걷기를 어싱 이라고도 한다.
엄밀히 말하면,
맨발 걷기는 Bare foot walking 이고, 어싱은 접지 Earthing 이다.
그래서, 맨발 걷기는 반드시 천천히 걸어야 한다. 맨발로 서 있어도 좋다.
왜냐하면, 땅과 접지 시간을 늘려야 하기 때문이다.
모든 생명체는 땅에 뿌리를 박고 살도록 설계되어 있다.
식물은 땅에 뿌리를 박고 생존한다. 모든 동물도 발로 땅을 접지하고 생활한다. 물고기도 물 밑에 땅과 접지 되어 있다. 인간만이 신발을 신으면서 접지가 안되고 절연 상태로 살아간다.
모든 기계, 전기, 전자 장치도 항상 땅과 접지, 어싱 Earthing 되어야 한다. 그래서 접지선이 있는 것이다.
셋째, 천연의 신경 안정 효과. 스트레스 호르몬인 코르티솔 분비가 안정화 된다.
땅을 밟으면서, 맨발 걷기를 하면 스트레스 호르몬, 코르티솔 호르몬 분비가 줄어든다는 연구 결과가 있다. (근거 : Journal of Alternative and Complimentary Medicine, 2004)
우리는 평생, 땅과 접지를 못하고, 차단된 상태로 살고 있다.
“어싱” 책에 의하면,
구두 신은 상태에서 땅과의 접지가 차단된 상태에서 몸의 전압을 재면 300 ~ 600 mV 다.
신발 없이 맨발이 땅과 접하는 순간 예외 없이 0 V로 떨어진다.
우리 몸에서는 양전하를 띤 활성 산소가 생성된다.
활성 산소는 모든 만성질환과 염증의 원인이다.
注) 활성 산소 : 원자핵 궤도에서 짝 지은 전자는 안정적이다. 하지만, 짝을 잃은 전자는 짝을 이루기 위해 전자를 찾으려고 한다. 즉 활성 (Free Radical, highly reactive) 된다. 전자가 부족하기 때문에 양전하로 표현한 것이다
땅 속에는 자유 전자가 무궁무진하게 있다.
맨발 걷기를 하는 순간, 양전하를 띤 활성 산소가 음전하인 땅의 자유 전자를 만나 중화된다.
생명의 자유 전자로 작동하게 되는 것이다.
땅에 접지를 하면, 적혈구의 제타 전위 (zera potential)가 높아진다.
그러면 세포 간에 밀어내는 힘을 나타내는 제타 전이가 2.7배 올라간다. 그래서 혈액이 맑아지고 점성도 묽어진다.
천연의 혈액 희석 효과가 나타난다. 그래서, 혈류의 속도가 올라가고, 혈전도 줄어든다.
매발 걷기는 무해한 천연의 아스피린을 먹는 것과 같다.
땅 속을 흐르는 자유 전자들이 몸 안으로 들어오게 하는 접지 효과 다.
네째, 천연으로, 활력을 증진 시키는 아데노신3인산 (ATP) 생성이 촉진되는 효과가 있다.
ATP는 에너지 대사의 핵심 물질, 세포에서 다양한 생명 활동을 수행하기 위해 에너지를 공급하는 유기 화합물 이다.
신선한 야채와 과일 섭취할 때 ATP가 생성된다.
땅을 밟으면, 땅속에서 전자가 올라와서 세포의 미토콘드리아 발전소를 작동하게 한다. 그러면 ATP가 생성되도록 도와준다.
신발을 신고 걸으면 에너지가 방전되고, 맨발로 걸으면 에너지가 충전된다.
다섯째, 발가락 구조 이론 (발가락 아치)
레오나르도 다빈치는 발의 아치 구조는 인체 공학의 결정품 이라고 했다.
발의 구조를 보면, 조물주가 만든 최고의 걸작품이란 것을 알 수 있다.
맨발로 걸으면 발바닥 아치가 압축, 이완을 반복 한다. 최고의 스프링 작용을 한다.
족저근막염, 무릎 관절염, 척추관 협착증, 경추의 통증, 질병이 생기는 원인은 우리가 신발을 신고 살면서 신발 바닥에는 깔창이라는 아치에 딱 맞게 디자인 한 신발을 신기 때문에 발이 스프링 역할을 제대로 못하기 때문이다.
발가락을 10개로 만든 이유는 정 자세로 제대로 작동을 하도록 하기 위한 조물주의 배려 다.
맨발 걷기 효과 3가지 (김범수 교수)
세계적으로 맨발 걷기가 유행하고 있다. 국내 많은 곳에 맨발 걷기 산책로가 조성되어 있다. 등산하면서도 맨발로 걷는 사람을 자주 보게 된다.
맨발 걷기의 효과는,
첫째, 발 근육이 자극되어, 발의 잔 근육 운동이 된다.
둘째, 둔해진 발의 감각을 깨우는 효과가 있다. 자연의 여러 자극을 느끼게 해 준다. 발의 고유 감각이 살아 난다. 따라서 균형 감각이 좋아진다.
셋째, 자연 지압 효과와 마사지 효과로 뻣뻣해진 근막을 이완 시켜 주는 효과가 있다.
따라서, 몸의 손상을 예방하는 효과가 있다. 지압과 마시지 효과로 혈액 순환도 원활해지고 좋아진다. 또한, 발의 노폐물 제거도 원활하게 좋아진다.
맨발 걷기 안전 수칙 7가지
첫째, 간단한 준비 운동으로 근육과 관절을 풀어준다.
둘째, 걸을 때는 앞의 1~2 m의 지면을 항상 응시 한다.
셋째, 발걸음을 똑바로, 수직으로 항상 내딛도록 걷는다.
넷째, 사람들이 걷는 길 밖의 풀 숲은 맨발로 들어가지 않는다.
다섯째, 비탈 경사 면을 내려올 때 미끄러지지 않도록 유의한다. 안전한 흙 길, 황톳 길을 추천한다
여섯째, 파상풍 예방 접종을 실시 한다.
파상풍, 디프테리아, 백일해 3가지를 한번 주사로 예방 접종을 받을 수 있다. 비용은 4만원 ~ 5만원 수준이다. 면역 형성 기간은 개인 차는 있지만, 2주~4주 정도 걸린다.
일곱째, 맨발 걷기를 한 다음, 발을 꼼꼼히 세척한다.
맨발 걷기 주의 사항
건강에 좋은 맨발 걷기도 잘못하게 되면 독이 된다. 따라서 주의 사항을 숙지하고 지키자.
첫째, 맨발 걷기 준비와 점차적으로 적응을 해 가는 과정이 필요하다.
수십 년 동안 맨발로 사용하지 않아서 많이 약해진 발로 맨발 걷기를 갑자기 하다 보면, 없던 병도 생길 수 있다. 따라서, 훈련과 준비가 필요하다. 처음부터 맨발 걷기로 만 보 걷기에 도전하면 큰일 난다.
둘째, 날카로운 것에 다치지 않도록 바닥을 잘 살피면서 걸어야 한다.
발의 심한 변형이 있거나 발바닥에 굳은 살이 많이 박히신 분들은 굳은 살 부분으로 압력이 집중된다. 따라서 통증이 심해지거나, 무리하게 되면 발바닥에 궤양이나 상처가 생길 수도 있다
셋째, 지방패드위축증후군이 있는 분들에게도 권장하지 않는다.
왜냐하면 발바닥의 패드 역할을 하는데 문제가 있기 때문이다.
족저근막염이나 지간신경종으로 통증이 심한 경우, 맨발 걷기가 증세를 악화 시킬 수 있으니 맨발 걷기를 권장하지 않는다.
당뇨병성 신경병증으로 발의 감각이 저하되신 분들, 혈액 순환 장애로 상처가 생기면 잘 낫지 않는 분들은 맨발 걷기는 금기 다.
맨발 걷기가 발 건강에 도움이 될 수는 있지만, 필수적인 것은 아니다.
최근 조사 결과에 의하면, 족저근막염, 후천성 평발, 무지외반증 모두 환자가 증가 추세에 있다.
아직 까지 맨발 걷기 연구는 시작 단계다.
따라서, 맨발 걷기에 대한 연구 결과는 아직 부족하다. (출처 : 서울대병원 유방내분비외과 한원식교수, 생로병사의 비밀, 맨발이면 청춘이다)
신발에 뒷 굽이 있는 이유는 걷기 편하게 하기 위해서 다.
갑자기 맨발로 걸으면 걷기가 불편해지만, 발의 운동 효과는 증가한다.
Earthing
맨발 걷기, 어싱(earthing)은 인간이 맨발로 땅 위를 걷거나 맨발로 땅에 몸을 대는 것을 말한다.
우리 몸과 지구 사이의 물리적인 접촉을 통해 지구의 자연적인 전하를 체내로 흡수하는 것을 목적으로 한다.
맨발 걷기, 어싱 지지자들은 지구와 몸의 접촉을 통해 몸에 쌓인 불균형한 전하를 방전하고, 지구의 음극성 자연 전하를 흡수할 수 있다고 주장한다.
맨발 걷기의 효과로 염증 감소, 스트레스 감소, 불면증 개선으로 수면 향상, 면역력 향상 등 다양하다.
맨발 걷기는 땅과 접지 효과를 통해서 활성 산소가 배출되는 효과가 있다. (출처 : 맨발학교 회장 장기현)
몸의 활성 산소 (+ 전하)와 땅의 자유 전자 (- 전하)가 작용하기 때문이다.
활성 산소를 효과적으로 없애는 방법 중 하나는 유산소 운동이다.
땀이나 호흡하면서 활성 산소가 배출된다.
단 무리한 운동은 활성 산소 생성을 촉진하기 때문에 신체 산화로 노화나 근골격계 질환을 유발할 수도 있다.
맨발 걷기의 7가지 걸기 방법
두꺼비처럼 걷기, 황새처럼 걷기, 까지 발 걷기, 잇몸을 우물거리듯 걷기, 주걱을 엎어 놓은 듯 걷기, 스탬프 찍듯이 걷기, 가재처럼 뒤로 걷기.
추운 겨울에도 맨발 걷기가 좋은가
추운 겨울에도 맨발 걷기는 건강에 도움이 된다.
왜냐하면, 적절한 스트레스 (적절한 추위, 적절한 더위, 적절한 배고픔)는 면역력을 증진시키고, 장수 유전자를 깨우기 때문이다.
예로, 적절한 추위는 냉수 마찰, 겨울 맨발 걷기, 적절한 더위는 반신욕, 적절한 배고픔은 간헐적 단식 등을 말한다.
우리 몸에는 체온 조절을 위한 땀샘이 400만 개 있다. 400만 개 땀샘은 모두 교감신경과 연결되어 있다.
땀샘의 50 퍼센트인 200만 개가 손과 발에 있다. 따라서, 겨울에 차가운 땅에서 30분 정도 맨발로 걸으면 냉수 마찰을 하는 효과가 있기 때문이다..
맨발 걷기, Earthing 어싱을 해서 모두 건강 하십시오.
출 처
ⓐ MBC 다큐프라임, 맨발 걷기, 몸속의 활성산소를 제거하는 효과적인 방법, 2023.02.12. 방송,
ⓑ 생로병사의 비밀, 맨발이면 청춘이다, 맨발로 걸을때 몸의 변화, 2017.08.23.
ⓒ 유튜브, 맨발 걷기, 접지 외 긍정 효과 및 주의사항, 김범수교수의 발편한 세상, 연세대 의학박사, 인하대 정형외과,
ⓓ 맨발로 걸어라, 박동창 지음, 국일미디어, 땅이 주는 치유의 선물. 돈이 안 들고 부작용이 없는 최고의 자연 치유요법
ⓔ [#EBS평생학교] 유튜브, 맨발 걷기 이론, 박동창의 맨발로 걸어라
ⓕ KBS 생로병사의 비밀 2023.7.12 방송 – 맨발로 걸으면 생기는 일
ⓖ KBS 무엇이든 물어보세요.. 2023.8.25 방송
ⓗ 유튜브, 맨발걷기 박성태교수 심층 인터뷰 (2023.9.10)
ⓘ 유튜브, 김자영의 미토TV, 암 환자에게 추운 겨울 맨발걷기, 해도 될까?
글쓰기 2023.07.19. 업데이트 2025.04.07.